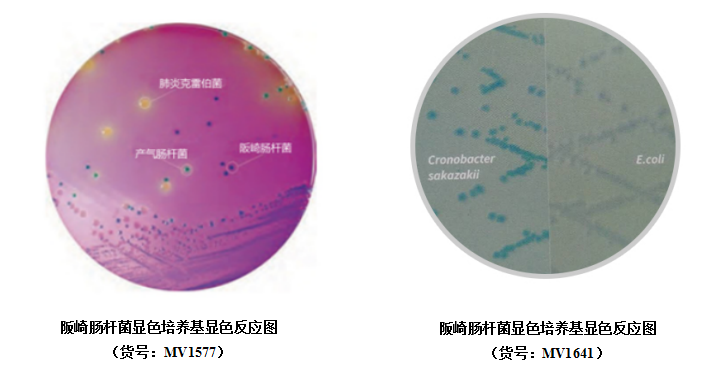
HKK4}M)L4A6AV(A`86MT7SY.png

北京缔一生物科技有限公司品牌商
9 年
手机商铺
- NaN
- 0
- 0
- 1
- 0
推荐产品
公司新闻/正文
检测阪崎肠杆菌,Hicrome显色培养基来帮你
153 人阅读发布时间:2018-10-08 16:59
阪崎肠杆菌曾被命名为黄色阴沟肠杆菌,是众多肠杆菌科属种类中的一种,一种周生鞭毛、能运动、无芽孢的革兰阴性细菌。该菌自1961 年被首次报道引起脑膜炎病例以来,在全球范围内相继出现该菌引起的病例。阪崎肠杆菌主要感染儿童,特别是引起新生儿严重的脑膜炎、败血症和坏结肠炎,甚至引起神经系统后遗症或导致死亡。
由于该菌主要感染人群为新生儿,我国对婴儿配方奶粉中阪崎肠杆菌微生物标准也逐渐提高。近年来,随着婴幼儿感染的报道逐渐增多,国际和国内相关机构都对婴儿配方奶粉中微生物危害控制的重要性也有了足够的认识。目前,我国对食品中阪崎肠杆菌的检测依据国标GB4789.40—2016,具体检查程序如下。

相信经常做实验的我们都知道,检测该菌的最主要步骤就是分离菌种啦,这直接决定着实验的成败。国标操作的第三步,涉及到应用显色培养基分离阪崎肠杆菌,这里就推荐各位实验操作人员选择由威正翔禹|北京缔一生物科技有限公司代理的HiMedia公司(国际知名微生物培养基生产商)生产的Hicrome显色培养基进行菌种分离鉴定。
HiMedia公司这可是全球发展最快的培养基生产厂家,是全球微生物培养三大顶尖品牌中,技术研发的公司。
在HiMedia的工厂里,应用世界级高技术生产工艺,生产有种类完整的微生物培养基,包括颗粒培养基、植物源性培养基(HiVegTM)、化学限定培养基(HiCynthTM)和显色培养基(HiCromeTM)。
我们检测阪崎肠杆菌可选择非常好用的阪崎肠杆菌显色培养基(货号:MV1577),该培养基适用于从食物、牛奶和奶制品中分离鉴定阪崎克罗诺杆菌属(阪崎肠杆菌);若检测进出口食品依据国际标准可选用另一款崎肠杆菌显色培养基(货号:MV1641),该培养基遵循ISO /TS 22964:2006。
HiMedia显色培养基产品更丰富,而且常用的培养基由植物源性蛋白成分或化学限定成分组成,性能等于或优于动物源性产品,安全性却更高,避开疯牛病风险和转基因植物风险,同时也具有更高的可重复性,说到这里相信,充满好奇的你一定喜欢。
不仅如此,国内外也有好多科研学者应用我们的产品呢?不信你瞧!
产品引用文献
1. M.Garbowska, A.Berthold-Plutab,L.Stasiak-Różańska.Microbiological quality of selected spices and herbs including the presence of Cronobacter spp.Food Microbiology.2015,49:1-5
2. MS El-Gamal,RKE Dairouty,AY Okda,SH Salah,SM El-ShamyIncidence and interrelation of Cronobacter sakazakii and other foodborne bacteria in some milk products and infant formula milks in Cairo and Giza area.World Applied Sciences Journal.2013, 26(9):1129-1141
3. Sang-Hyun Park, Dong-Hyun Kang. Fate of biofilm cells of Cronobacter sakazakii under modified atmosphere conditions. LWT - Food Science and Technology. 2014,57( 2):782-784
4. Muna T. Al.Mossawi, Yasmin S. H. Al.joubori.Detection of Cronobacter sakazakii (Enterobacter sakazakii) in powdered food infants (PIF) and raw milk in Iraq.Baghdad Science Journal.2015,12(1):63-71







